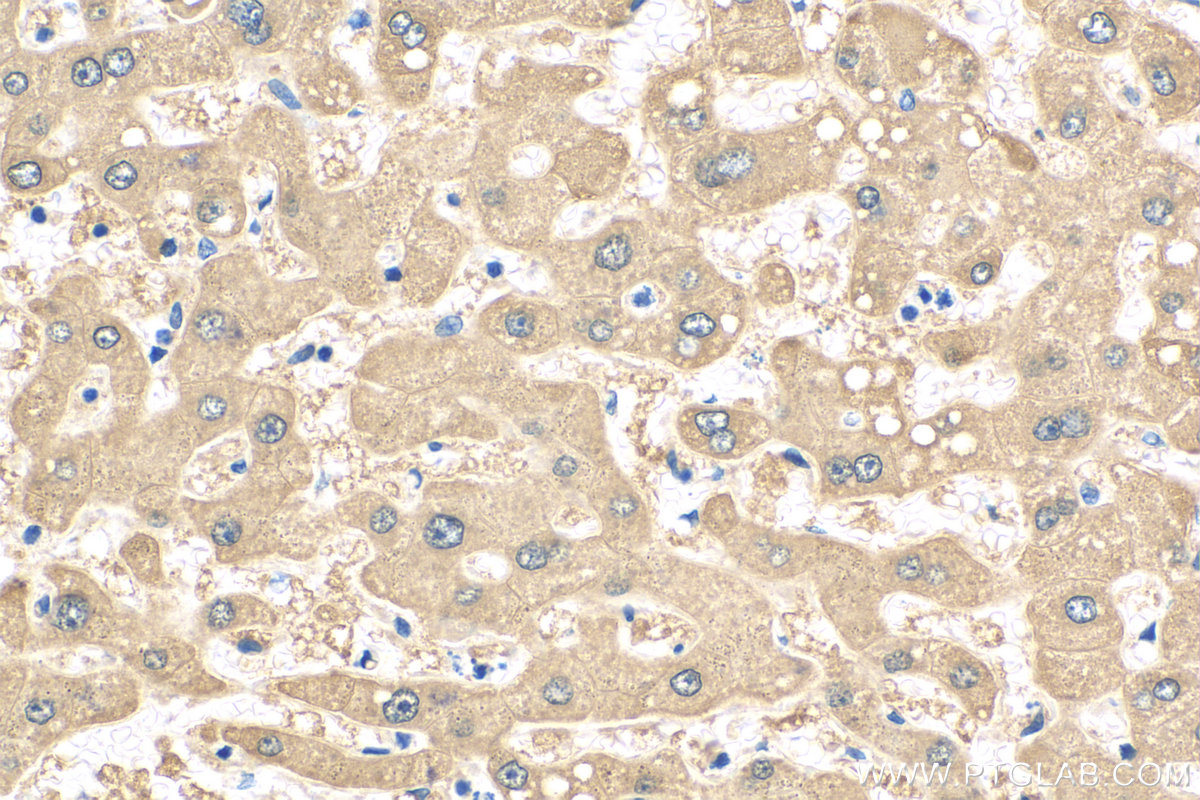

验证数据展示
经过测试的应用
| Positive WB detected in | L02 cells, mouse kidney tissue, mouse liver tissue, rat liver tissue |
| Positive IHC detected in | human hepatocirrhosis tissue Note: suggested antigen retrieval with TE buffer pH 9.0; (*) Alternatively, antigen retrieval may be performed with citrate buffer pH 6.0 |
| Positive IF/ICC detected in | HepG2 cells |
推荐稀释比
| 应用 | 推荐稀释比 |
|---|---|
| Western Blot (WB) | WB : 1:1000-1:5000 |
| Immunohistochemistry (IHC) | IHC : 1:50-1:500 |
| Immunofluorescence (IF)/ICC | IF/ICC : 1:50-1:500 |
| It is recommended that this reagent should be titrated in each testing system to obtain optimal results. | |
| Sample-dependent, Check data in validation data gallery. | |
产品信息
21602-1-AP targets ALDH8A1 in WB, IHC, IF/ICC, ELISA applications and shows reactivity with human, mouse, rat samples.
| 经测试应用 | WB, IHC, IF/ICC, ELISA Application Description |
| 经测试反应性 | human, mouse, rat |
| 免疫原 |
CatNo: Ag16214 Product name: Recombinant human ALDH8A1 protein Source: e coli.-derived, PGEX-4T Tag: GST Domain: 136-487 aa of BC113862 Sequence: CMHYTVRAPVGVAGLISPWNLPLYLLTWKIAPAMAAGNTVIAKPSELTSVTAWMLCKLLDKAGVPPGVVNIVFGTGPRVGEALVSHPEVPLISFTGSQPTAERITQLSAPHCKKLSLELGGKNPAIIFEDANLDECIPATVRSSFANQGEICLCTSRIFVQKSIYSEFLKRFVEATRKWKVGIPSDPLVSIGALISKAHLEKVRSYVKRALAEGAQIWCGEGVDKLSLPARNQAGYFMLPTVITDIKDESCCMTEEIFGPVTCVVPFDSEEEVIERANNVKYGLAATVWSSNVGRVHRVAKKLQSGLVWTNCWLIRELNLPFGGMKSSGIGREGAKDSYDFFTEIKTITVKH 种属同源性预测 |
| 宿主/亚型 | Rabbit / IgG |
| 抗体类别 | Polyclonal |
| 产品类型 | Antibody |
| 全称 | aldehyde dehydrogenase 8 family, member A1 |
| 别名 | EC:1.2.1.32, ALDH8A 1, ALDH12, 2-aminomuconic semialdehyde dehydrogenase |
| 计算分子量 | 487 aa, 53 kDa |
| 观测分子量 | 53 kDa |
| GenBank蛋白编号 | BC113862 |
| 基因名称 | ALDH8A1 |
| Gene ID (NCBI) | 64577 |
| RRID | AB_10733887 |
| 偶联类型 | Unconjugated |
| 形式 | Liquid |
| 纯化方式 | Antigen affinity purification |
| UNIPROT ID | Q9H2A2 |
| 储存缓冲液 | PBS with 0.02% sodium azide and 50% glycerol, pH 7.3. |
| 储存条件 | Store at -20°C. Stable for one year after shipment. Aliquoting is unnecessary for -20oC storage. |
实验方案
| Product Specific Protocols | |
|---|---|
| IF protocol for ALDH8A1 antibody 21602-1-AP | Download protocol |
| IHC protocol for ALDH8A1 antibody 21602-1-AP | Download protocol |
| WB protocol for ALDH8A1 antibody 21602-1-AP | Download protocol |
| Standard Protocols | |
|---|---|
| Click here to view our Standard Protocols |